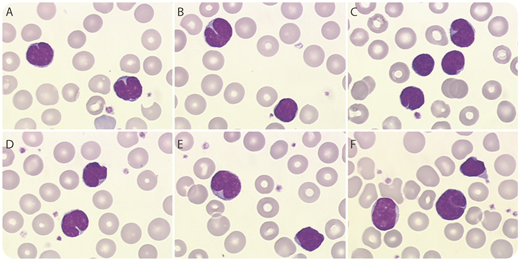
A 1-month-old child was admitted with a cough of 1 week’s duration. The blood count revealed marked leukocytosis (45.9 × 109/L) with a predominance of lymphocytes (76%). The lymphocytes were polymorphous but many had a cleft nucleus (panels A-F; May-Grünwald-Giemsa stain, original magnification ×100), suggestive of lymphoma (eg, follicular lymphoma or Sézary syndrome). This cytological presentation together with the clinical findings were typical of “malignant whooping cough.” Positive polymerase chain reaction testing for Bordetella pertussis, carried out on a nasopharyngeal swab, confirmed the diagnosis. / Pertussis (whooping cough) is an acute bacterial disease of the airways caused by a gram-negative bacterium, B pertussis. Its transmission is airborne and highly contagious. Lymphocytosis is mainly seen in children and is an indicator of the severity of the infection, with a risk of pulmonary leukostasis when the counts exceed 100 × 109/L. Whooping cough is a life-threatening disease, particularly in infants younger than 3 months of age. In areas with low rates of vaccination, immunocompromised patients and young infants are at particular risk from multiple highly contagious infections such as measles. Even in areas with high rates, immunity to pertussis wanes and booster shots are needed to ensure adequate immunity. Women and/or those with infants must be strongly encouraged to be vaccinated to prevent infection in the vulnerable.

A 1-month-old child was admitted with a cough of 1 week’s duration. The blood count revealed marked leukocytosis (45.9 × 109/L) with a predominance of lymphocytes (76%). The lymphocytes were polymorphous but many had a cleft nucleus (panels A-F; May-Grünwald-Giemsa stain, original magnification ×100), suggestive of lymphoma (eg, follicular lymphoma or Sézary syndrome). This cytological presentation together with the clinical findings were typical of “malignant whooping cough.” Positive polymerase chain reaction testing for Bordetella pertussis, carried out on a nasopharyngeal swab, confirmed the diagnosis.
Pertussis (whooping cough) is an acute bacterial disease of the airways caused by a gram-negative bacterium, B pertussis. Its transmission is airborne and highly contagious. Lymphocytosis is mainly seen in children and is an indicator of the severity of the infection, with a risk of pulmonary leukostasis when the counts exceed 100 × 109/L. Whooping cough is a life-threatening disease, particularly in infants younger than 3 months of age. In areas with low rates of vaccination, immunocompromised patients and young infants are at particular risk from multiple highly contagious infections such as measles. Even in areas with high rates, immunity to pertussis wanes and booster shots are needed to ensure adequate immunity. Women and/or those with infants must be strongly encouraged to be vaccinated to prevent infection in the vulnerable.
A 1-month-old child was admitted with a cough of 1 week’s duration. The blood count revealed marked leukocytosis (45.9 × 109/L) with a predominance of lymphocytes (76%). The lymphocytes were polymorphous but many had a cleft nucleus (panels A-F; May-Grünwald-Giemsa stain, original magnification ×100), suggestive of lymphoma (eg, follicular lymphoma or Sézary syndrome). This cytological presentation together with the clinical findings were typical of “malignant whooping cough.” Positive polymerase chain reaction testing for Bordetella pertussis, carried out on a nasopharyngeal swab, confirmed the diagnosis.
Pertussis (whooping cough) is an acute bacterial disease of the airways caused by a gram-negative bacterium, B pertussis. Its transmission is airborne and highly contagious. Lymphocytosis is mainly seen in children and is an indicator of the severity of the infection, with a risk of pulmonary leukostasis when the counts exceed 100 × 109/L. Whooping cough is a life-threatening disease, particularly in infants younger than 3 months of age. In areas with low rates of vaccination, immunocompromised patients and young infants are at particular risk from multiple highly contagious infections such as measles. Even in areas with high rates, immunity to pertussis wanes and booster shots are needed to ensure adequate immunity. Women and/or those with infants must be strongly encouraged to be vaccinated to prevent infection in the vulnerable.
For additional images, visit the ASH Image Bank, a reference and teaching tool that is continually updated with new atlas and case study images. For more information, visit http://imagebank.hematology.org.